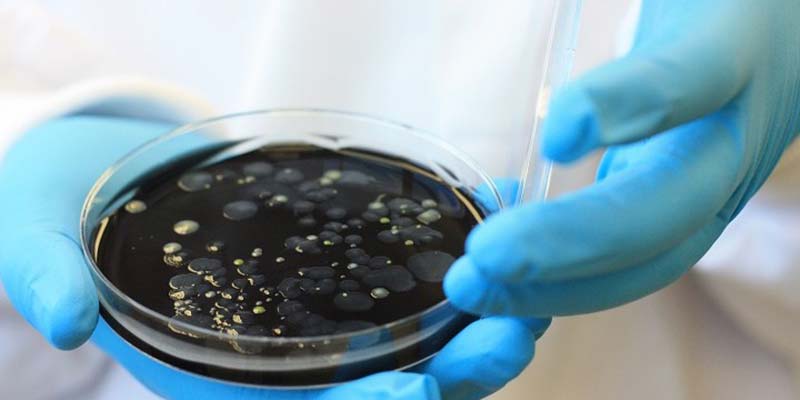

Il y a eu une baisse significative des cas de Maladie du légionnaire dans la région nord du Portugal depuis l'arrêt des tours de refroidissement d'une usine de Matosinhos, a révélé ce dimanche l'Administration régionale de la santé du Nord.
"Depuis la suspension du fonctionnement des tours de refroidissement susmentionnées, il y a eu une diminution marquée du nombre de cas de légionellose dans la zone géographique susmentionnée", a déclaré l'Administration régionale de la santé du Nord dans un communiqué ce dimanche, selon Agence de presse Lusa.
Au début du mois, les autorités sanitaires portugaises ont détecté des légionelles dans les tours de refroidissement du centre de distribution de Longa Vida à Matosinhos, Porto.
Longa Vida a déclaré dans un communiqué qu'elle avait éteint les tours et que la bactérie avait été découverte par les autorités le 10 novembre. Cependant, la société a déclaré qu'elle n'avait reçu aucune information concernant une éventuelle corrélation avec la récente épidémie de légionellose en la partie nord du pays.
La légionellose est une infection pulmonaire de type pneumonie causée par la bactérie Legionella et elle est contractée en respirant des gouttelettes d’eau contenant la bactérie, qui peuvent se développer dans des tours de refroidissement, des spas, des douches et d’autres sources d’eau.
Selon les autorités sanitaires portugaises, 88 personnes ont été diagnostiquées avec la maladie depuis le 29 octobre et 10 personnes sont décédées. Le ministère public a annoncé l'ouverture d'une enquête pour enquêter sur les causes de l'épidémie.